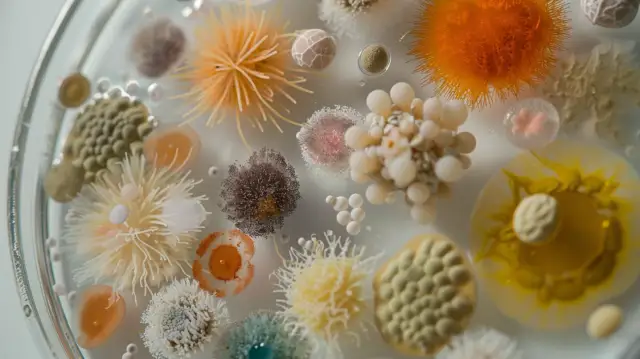
Co to są patogeny - jakie są ich rodzaje i jak wpływają na zdrowie?

Wzdęcia u noworodka: Przyczyny i metody postępowania
Skąd się biorą wzdęcia u noworodków i jak sobie z nimi radzić? Poznaj przyczyny co na wzdęcia u noworodka, objawy i domowe sposoby leczenia tej częstej przypadłości okresu niemowlęcego.

Skąd się biorą wzdęcia u noworodków i jak sobie z nimi radzić? Poznaj przyczyny co na wzdęcia u noworodka, objawy i domowe sposoby leczenia tej częstej przypadłości okresu niemowlęcego.

Poznaj przyczyny bolesnych wzdęć brzucha i dowiedz się, jak sobie z nimi poradzić. Odkryj skuteczne sposoby na złagodzenie uciążliwych bólów brzucha i wzdęć.

Odkryj tajniki Bifidobacterium infantis 35624 – wyjątkowego szczepu probiotycznego pochodzącego z przewodu pokarmowego niemowląt. Poznaj jego właściwości, bezpieczeństwo stosowania i korzyści dla zdrowia.

Dowiedz się wszystkiego o objawach skórnych celiakii - objawy, zdjęcia, leczenie. Odkryj, jak rozpoznać i radzić sobie z problemami skórnymi przy celiakii u dorosłych i dzieci.
Czym są patogeny? To organizmy chorobotwórcze, takie jak wirusy, bakterie, grzyby i pasożyty. Poznaj ich rodzaje, źródła, jak wpływają na zdrowie i jak się chronić!

Poznaj nową generację IMO prebiotyków - substancji, które mogą znacząco poprawić Twoje zdrowie i samopoczucie. Dowiedz się, jak wykorzystać je w codziennej diecie i suplementacji.

Otrzymanie ujemnego wyniku testu na antygen Helicobacter w kale może mieć różne znaczenie. Dowiedz się, co może oznaczać ten wynik i jak dalej postępować w Twojej sytuacji.

Porównanie skuteczności i działania leków Berberyna a metformina. Sprawdź różnice w mechanizmach, zastosowaniach i profilu bezpieczeństwa, aby wybrać najlepsze rozwiązanie dla Twoich potrzeb zdrowotnych.

Blastocystis hominis polski to pasożyt jelitowy powodujący objawy pokarmowe i ogólnoustrojowe. Poznaj charakterystykę, symptomy oraz skuteczne blastocystis hominis leczenie i blastocystis hominis leczenie naturalne tego organizmu.

Przyczyny, objawy i skuteczne sposoby radzenia sobie z bólem i pieczeniem przy oddawaniu moczu po stosunku seksualnym. Dowiedz się, jak zapobiegać i leczyć tę dolegliwość.

Poznaj różne rodzaje grzybicy u dzieci, ich objawy i skuteczne metody leczenia. Dowiedz się, jak rozpoznać pierwsze oznaki infekcji grzybiczej i kiedy należy skonsultować się z dermatologiem. Profesjonalne porady i sprawdzone terapie.

Kompleksowy przewodnik dotyczący badania kału na pasożyty w Poznaniu. Poznaj ceny, najlepsze miejsca na badania kału pasożyty, badanie kału na bakterie, badanie kału u dzieci wyniki oraz porady dotyczące prawidłowego pobrania próbki kału w Poznaniu.

Choroby podobne do ADHD mogą naśladować objawy zaburzenia u dzieci. Nasz artykuł pomaga rozróżnić ADHD od innych schorzeń, takich jak zaburzenia lękowe lub autyzm. Dowiedz się o wczesnej diagnostyce i skutecznych metodach leczenia.

Rozpoznanie i leczenie ADHD u niemowląt to wyzwanie. Poznaj objawy, skuteczne testy, metody terapii behawioralnej oraz diety łagodzące objawy ADHD u małych dzieci.

Odkryj korzyści płynące z fruktooligosacharydów - naturalnych prebiotyków, które wspierają zdrowie układu pokarmowego. Poznaj źródła tych cennych węglowodanów w codziennej diecie.

Dowiedz się, jak prawidłowo interpretować wyniki badania Candida w kale. Poznaj objawy, metody diagnostyczne i skuteczne sposoby leczenia nadmiernego rozwoju grzybów w przewodzie pokarmowym. Sprawdź normy i zalecenia.

Poznaj skuteczne sposoby na radzenie sobie z gazami, wzdęciami i odbijaniem. Odkryj dietę przeciwgazową, korzyści z probiotyków, ziołowe remedium i ćwiczenia zwalczające te dolegliwości trawienne.

Biorezonans to kontrowersyjna, ale intrygująca metoda terapeutyczna wykorzystująca fale elektromagnetyczne. Co to biorezonans? Odkryj zasadę jego działania i możliwości zastosowania w leczeniu różnych schorzeń.

Poznaj historię badań krwi na alergie pokarmowe - od pierwszych testów po nowoczesne metody diagnostyczne. Sprawdź, jak rozwój technologii zmienił wykrywanie alergii i gdzie w Warszawie wykonasz kompleksowe badania.

Czy bakterie na odchudzanie rzeczywiście wspomagają utratę wagi? Poznaj działanie probiotyków, takich jak Lactobacillus gasseri i ich wpływ na metabolizm oraz apetyt.